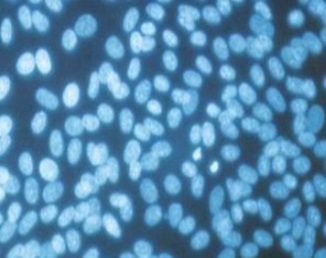

CD Formulation can provide one-stop services for contaminants analysis includingmicrobiological testing(e.g., bacterial and fungi testing, sterility testing, mycoplasma testing), bacterial endotoxin testing andviruses residue testing.
Why to Perform Contaminants Analysis?
Biological products have developed rapidly due to their stronger specificity, ability to bind to molecular targets, good efficacy, and fewer side effects. However, biological products have diverse components, complex structures, and different production processes, making them more susceptible to contaminants during the preparation process. Common contaminants refer to exogenous substances brought in, such as pathogenic microorganisms carried by biological raw materials (e.g.,bacteria, mycoplasma, mycobacteria, endogenous viruses and viruses contaminated from the outside).These contaminants will not only affect the efficacy of biological drugs, but may also pose safety hazards. Therefore, the drug development and production processes require strict quality control.
Our Services for Contaminants Analysis
CD Formulation will develop personalized proposals to perform contaminants analysis for bio-pharmaceuticals based on the customer's needs. We can provide a series of contaminant analysis services for global researchers, including but not limited to:
The rapid development of bio-pharmaceuticals is inseparable from the basic guarantee of quality control. As a key safety indicator for quality control of biological products, microorganisms are a key parameter for process control and product release. Microbiological testing items involved in biological products include bacteria, fungi, mycoplasma, etc.
- Bacterial and Fungi Testing

Bacteria and fungi can be considered important contamination sources for all kinds of pharmaceutical products, including bio-pharmaceuticals. Hence, the control of them is of critical importance. The control of both bacteria and fungi is considered to be worthy of mandatory tests for nearly all kinds of pharmaceuticals in pharmacopoeias. We can detectbacteria and fungiby standard sterility testing or macroscopic and microscopic characteristics, as well as biochemical tests.

Mycoplasma contamination not only leads to a decrease in the quality of biological products, but also reduces their expression levels, ultimately leading to lower yields and adverse side effects for patients. We can provide the maycoplasma testing with the following methods, such as based on culture method, NAT (nucleic acid amplification method) method, and cell culture indicator method.

Sterility testing is to inoculate the test product or its extract into the culture medium to check whether the test product has microbial contamination. This testing is conducted by direct inoculation or membrane filtration methods and can be performed in an isolator or cleanroom environment. We have lots of experience in sterility testing with this method.
- Bacterial Endotoxin Testing
The bacterial endotoxin test method is a method that uses limulus reagent to detect or quantify bacterial endotoxins produced by Gram-negative bacteria to determine whether the bacterial endotoxin content in the test product meets the regulations. The reaction mechanism of the limulus reagent method is a reaction in which bacterial endotoxin activates a series of coagulase enzymes in the limulus hemocyte lysate with the participation of divalent cations. It includes two methods, namely gel method and photometric method, the latter including turbidity method and chromogenic matrix method. We always provide the bacterial endotoxin test with the gel method or photometric method to meet the customer's different requirements.
Viral contamination is an important risk that threatens the safety of therapeutic biological products. At CD Formulation,viruses can be detected via a number of methods such as co-cultivation assays (specific in vitro tests), in vivo assays, antibody production in animals (MAPs, RAPs, or HAPs), immunoassays for viral specific proteins, TEM, or PCR. We can provide the customers with the following viruses residue testing services.
- Hepatitis B&C Detection
- Influenza Virus Detection
- HIV Detection
- Coxsackieviruses Detection
- HSV Detection
- Enteric Virus Detection
- H1N1 Detection
- H3N2 Detection
- H3N3 Detection
- H6N6 Detection
- RSV Detection
- HCoV-229E Detection
- FCV Detection
- HPV Detection
- HSV Detection
- NV Detection
- AIV Detection
- EV71 Detection
- Adenovirus HAdVs-A Detection
- Cox A16 Detection
- CDV Detection
- CAVⅠ Detection
- CAVⅡ Detection
- CCV Detection
- HECV Detection
- FMDV Detection
- HHV-8 Detection
- FHV-1 Detection
- GX/P2V Detection
- CVS-11 Detection
- MNV Detection
- MERS-CoV Detection
- CPV Detection
- ECHO11 Detection
- HIV Detection
- SARS Detection
- N5N7 Detection
- ASFV Detection
- Poliovirus Detection
- FPV Detection
- FRV Detection
- 229E Detection
Our Workflow for Contaminants Analysis
Here are following six steps to easily solve your requirements.

Advantages of Our Services
- Our laboratory is fully equipped to meet the different needs of contaminant testing for bio-pharmaceuticals.
- Our team have lots of experience in contaminants analysis, and can provide you with the professional proposal.
- We can arrange the most efficient testing services for your project.
- We have excellent after-sales service to solve your any issues.
How to Contact Us?
If you have a requirement about our services, please contact us by phone or email, our colleagues will reply to you within three working days.
Related Services